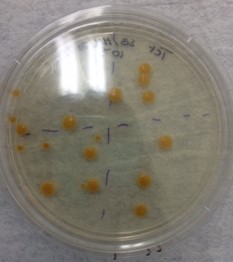
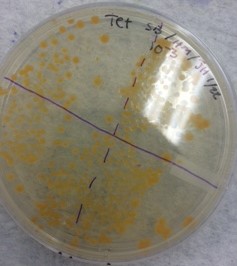
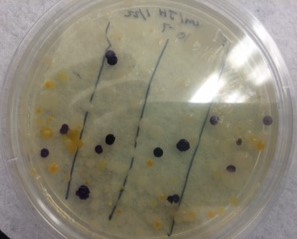
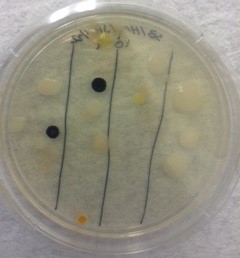

User:Justyne Hindley/Notebook/Biology 210 at AU
Transect Description on 1/15/16
Abiotic Factors:
lamp
sprinklers (4)
candy wrapper
Biotic Factors:
leaves
dry soil- closer to the edge of the transect closest to the walking path,
wet soil- throughout the transect where ever there was a sprinkler as well along the back wall,
1 big tree towards the North East side of the transect,
9-10 smaller dead trees scattered throughout the transect,
8 scattered patches of grass,
2-3 clover clumps
Protists and Algae 1/22/15
To set up the Hay Infusion, 12 grams of soil and vegetation were added to a plastic jar. 500mL of deerpark
water and 0.1 gram of dried milk were added to the jar before all the contents were swirled together.
The jar was then left open to sit for seven days before being re-observed.
The hay infusion smells of something rotten,maybe rotten eggs. The water is a clouded murky yellow and there appears to be some kind of brown mold growth growing on the surface of the water.
The top niche appeared to show mold growth around the leaf in the center as well as around the edge furthest away from the tape label (this will be referred to as the back of the jar in future entries).
The bottom niche appeared to be very calm. There seemed to be two kinds of mold growth both around plants and not. The mold seem to grow around the leaf and the grass shoot at the bottom of the jar.
Dichotomy
The description for each of the three dichotomies goes as follows: magnification, name, shape, size, color, description of organism(s)
Top: 40X, Gloecapsa, circle/ oval, 12.5 micrometers, green, motile, algae, and photosynthesizing
Middle: 10X, Arcella and Gloecapsa, circle/ oval, the Arcella was 25 micrometers and the Gloecapsa was 125 micrometers, white and green, motile, algae and photosynthesizing
Bottom: 10X, Amoeba and Arcella, circle/ oval, 125 micrometers and 25 micrometers, light green, motile to non-motile over time, protozoa and photosynthesizing
Diagram of the Serial Dilution for next lab
Organism: Arcella
1.organism is made of a single cell.
2. Use Pahagocytosis to eat
3. Is a part of a large phylum
4. Asexual
5. Have DNA
If the Hay Infusion were to grow for another two months, there would most likely not be as many living cells as what can be seen now. Depending on how each of the organisms survive, resources would eventually begin to diminish making it so that only the best organisms, or those with the best fitness could survive.
Microbiology 1/29/2016
To learn more about the bacteria growing on the augur plates, a wet mount and a gram stain were done
for one bacteria on each of the 8 plates, chosen to be observed.For this lab, Tetracycline positive
plates with a dilution of -3, -5, -7 and -9 were chosen along with tetracycline negative plates with
the dilution of -3, -9, -7, and -5. To complete the wet mount, a loop was sterilized over a flame before
a scrape was taken from a colony growing on a plate. The bacteria was then mixed with a drop of water on
a clean slide and covered with a cover slip before being observed at the 10X and 40X objectives. The same
processes was done for all 4 wet mounts.
To complete the gram stain, a loop was sterilized before a scrape of bacteria was taken from the same colony
on each plate. The bacteria was then mixed with a drop of water and a circle was drawn underneath the sample
on the bottom side of the slide. The slide was then heat fixed by passing the slide through a flame 3-5 times
with the bacterial side facing up. The bacteria was then was then covered with crystal violet for one minute
before being rinsed with DI water. After the rinse, the bacteria was covered with Gram’s Iodine for one minute
before being rinsed with DI water for a second time. The bacterial smear was then decolorized using 95% alcohol.
The slide was washed for about 10-20 seconds or until no more color was coming from the slide. The smear was then
covered with safranin red for 10-20 seconds before being rinsed for a third time. Any excess water was carefully
removed with a kimwipe before the gram stain was observed at both the 40X and 100X objectives. The same process was
done for each of the four slides.
Final Hay Infusion Observation:
Transect still smells like sulfur/ rotten eggs
Water is a darker yellow/ brown color
Leaves have fully sunken to the bottom but are still in tact
Small streaks of mold growing across the top of the water
Hypothesis: Over time, organisms will compete for resources which can cause more to grow and others to die off if there isn't enough resources to sustain them.
Archaea species will have most likely grown or not grown on the plate due to the conditions they were plated in and on.
Quantifying and Observing Microorganisms
Table 1: 100 fold Serial Dilution Results
The higher the dilution on either set of plates, the more colonies there were on each plate. However, overall the tetracycline negative plates had more colonies per plate than the tetracycline positive plates.
The tetracycline positive plates only had one type of bacteria growing on them while the tetracycline negative plates appeared to have 3 different types. Based on what was observed, only one type of bacteria was unaffected by the tetracycline.
Tetracycline+ plates with a dilution of -5 and -3
The bacteria was yellow in color and circular. All of the colonies appeared to have entire edges, appeared smooth and glistening as well as convex. This held true for both tetracycline positive plates being observed. The only difference was that the higher the dilution on the plate, the less bacteria there were.
Tetracycline+ -5
Tetracycline+ -3
Tetracycline- plates with a dilution of -7 and -9
Three different types bacteria grew on both tetracycline negative plates.
The first was a dark purple circular bacteria. The edges appeared udulateand the surface appeared wrinkled and rough. Overall the bacteria appeared slightly raised.
The second bacteria appeared to be creamy white and irregularly shaped in some places and circular in others. The edges however tended to consistently appear entire. Finally, the bacteria's surface appeared smooth and glistening and slightly raised.
The third bacteria appeared to be the same as the bacteria that grew on each of the tetracycline plates. It was yellow in color, circular and had entire edges. The surface appeared glistening and smooth and overall the colonies appeared to be convex.
Tetracycline- -7
Tetracycline- -9
None of the four plates observed had fungus growing on them.
Table 2: Bacteria Colonization Table
Sketched images in the following order: gram stain of Tetracycline+ -3 bacterial colony, gram stain of Tetracycline+ -9 bacterial colony, wet mount of Tetracycline- -3 bacterial colony, wet mount of Tetracycline- -9 bacterial colony, gram stain of Tetracycline+ -5 bacterial colony, wet mount Tetracycline+ -5 bacterial colony. Tetracycline+ -7 gram stain, tetracycline+ -7 wet mount. All sketches are what was seen at the 40X objective.
Mechanism of Tetracycline
Tetracycline is a tetracylines protein synthesis inhibitor whose main target is also the 30S ribosome (1). With the ability to work against aerobic gram positive and gram negative species, this protein synthesis inhibitors main goal is to inhibit protein translation by preventing the aminoacyl tRNA from binding to the ribosome (1).
Plants and Fungi 2/5/15
Characteristics of Plants Collected from the Transect
Leaves from the transect varied in size shape and color. While the grasses were found clustered with others
similar to it, the dead leaf was found on the ground by itself. Assuming it came from the tree in the transect,
it can be assumed it grew with others. The clover was also found growing on its own but there were others similar
to it throughout the transect. However, the leaves on the single clover appeared to grow in a group of 4. Finally,
the fern was also found broken on the ground within the transect; its leaves appear to grow
on their own but all together on a branch. All of the plants other than the single brown leaf were bright green in color. The fern branch was the largest, and then it went the leaf, the long grass, the short blade of grass and the clover.
We did not bring any seeds. In turn, vascularization and mechanisms of reproduction were deduced based on what was observed.
Fungi sporangia are black, globe like structures that hold spores. They are
important because when the spores are released they gather food for the fungi.
Observed Samples
1. Zygomycota- lichen
2. Ascomycota- bread mold
3. Not able to be seen
The bread mold at 40X under the dissecting microscope.
Invertebrates 2/12/15
For this lab, a Berlese Funnel was set up so as to be able to observe invertebrates from the transect. To set up the funnel, 25mL of a 50:50 ethanol/ water solution was added to a 50mL conical tube. A small amount of screening material was then taped to the inside of the funnel so that large pieces of the transect that would be added later would not fall into the solution. The conical tube was then parafilmed and taped to the bottom of the funnel so that it was attached but the funnel was not in the solution. The funnel and tube were set up on a ring stand about 2 inches under a 40 watt lap before a sample of leaf litter from the transect was added to the funnel. The funnel was covered with foil and left to sit for a week before any observations were taken.
Wikipedia Commons
Food Web
Vertebrates that may inhabit the Transect
These organisms live together in such a way that they create a community. Meaning they live based on the actions of each other. Some organisms will feed on others while others will be eaten. Some may also help clean up the community in such a way that others can live easier lives. While they can all live together, if there populations were to grow and, or new organisms came to live in the transect, more resources would need to be made available so as to care for every organisms. If this cannot happen, the transect will have reached its carrying capacity, meaning it has reached a point where it can only take care of what already lives in it.
The transect includes the following biotic and abiotic factors: Abiotic Factors:
lamp
sprinklers (4)
candy wrapper
Biotic Factors:
leaves
dry soil- closer to the edge of the transect closest to the walking path,
wet soil- throughout the transect where ever there was a sprinkler as well along the back wall,
1 big tree towards the North East side of the transect,
9-10 smaller dead trees scattered throughout the transect,
8 scattered patches of grass,
2-3 clover clumps
Ultimately, these factors benefit each species in that they provide both internal and external constant resources. However, not all factors will always be of benefit. For example, while the sprinklers provide a constant water supply if something were to happen to the system, or it broke, their may be to much or to little water available causing life to die off.
PCR Analysis- Done on 1/29/2016 Observed on 2/26/2015
PCR Gel: Observed samples are in wells two and four
1 MB14: NNNNNNNNNNNNNNNGNNANNNCNTGCNNNNNNANAGGAACGNANTCTTANGNTTCTCGGCAGAGGGGTGAGGGTGCGGT NAANNNGNGGAAACTGACGTGAGCNGGGGGAAGNNCTTNCCACCGGTANAGTANAACCCCCANATAAAAATCNAGGCAAC TCTCANTATGAACTGGTCCGGTGGATACAGNAGCNCTCGCCCCAGATGATACANTNGGTAGGGTAACGGCCCCCCACGTC TGTGATCTTTGTGGGGNCTGANANGNNGATCCCCCACACTGGTACGGANACACGGACCCNACACCTATGGGAGGNGGCTC AGATGAGCATTGGACNGTGGGTGANNGNNNGATNTGTACANCCNGTCTGNNATTGTANAGCNNTTTGGGTTGGANCNTAT TTTGNNGCGGGAACATTGNTCGCNNATGTTTCACGCTGAAGNTTNANTTTAAACTCTNTACGNNGNNGCCNNTTATACCA ACCGTGCACNCATTAATCGNANTTACTGANCNTANAGAATTNNANGTTTTTTGTTANTTGAACNTGAAACCNCGGGCTCA ACCTGGNACTGCATCCNAAACTGGCCAGCTAGANAAGGTCNANGGTGGTNCAATTTGCTGTGTACCTGTGAATGGNTAAT ATNTCACGGAACAAGAGTGCCGAATGCNACCNCCGNACGATACTGACACTGANTNCAGCCGCNTGCGAACAAACANNNTT AGATACCGTGGTNNTCTACGCCTNNGACNANGTCNACTANCANNGGNATCCTTNAGNTNNACTGNCGACCTCANCCNTTA ATTTGACCNNGGNNNAGTGCNNNNNCANNNNAANNTCNNAGNNATTTNAAGCCGCCCGCACGNGAGGAGGAGCNNGTNGT TNNNNTNNAANNGCNANAAAAGCTTNGCNNNNCCNNNCNGNGAGNNNANTTTNTTNNNNGNNATNAGTACNNTCNNNNA
There was no match for this PCR
2 MB15: NNNNNNNNNNNNNNNNNNNNNAAACNNNNNNNTNNNNNNNGGATCGNGGTNTAGTNNNGNNCTGNNNTGAGGAGTANGGG
AGNNNNNNNNNNNNNAGGNAAACTGCCNGATGGAAGGGGATAACTACNNGNANGGGNANCTAATACCGCACAACGTCNCA
NGACCAAGGAGGGGGACCTTCGGGCCTCTTGCCATCANATGTGCCCAGATGGGATTAGCTNGGAGGTGGGGTAATGGCTC
ACCTAGGCGACGATCCCTANCTGGTCTGANAGGATGACCAGCCACACTGGAACTGAGACACGGTCCACACTCCTACGGGA
GGCAGCANTGGGGAATATTGGGAATGGGCGCAGACCTGATGCGCCATGCCGCGTGTATNANNAACGCCTTCGGGTTNTAA
AGTACTTTCAACGAGGAGGAAGGCATTGAGGTTAATAACCCCNGTGATTGACGTTACTCNCAAAAAAAGCACCAGCTAAT
TCCNTGCCANGCGCCACTANTAATACGTGGNGGCGNNGCNTTAATTTACANTTACNGNGCNTAGAGCACGCGCNNGCGNN
CTTTCAANTCGGAANTNAAGTCCTCCNGCTCAGCCTGGGAACTGCNTTCNAGACTGNNANGCTGNAATCTTGTANAGAGA
ATGTANAATTCCNNATNTAACGGGTGAAATGCNNNGANAGATGAGGGGAATGCCCGTGGGGGCGNGTCGNNCCGNGGTGG
ANAGAGAGTGAGNCTAANGTGCGGGAAGGNTGGAGAGGATGAGAAGGATGCGATAGTCCNNNNNGTCGACNNGNNANACN
ATCTCAANNTNNNNTTNNNGCTCGNNNNNNGTNNCTGTCCGCANNNNAGGAGTTGACNNNGCCGCGCGGTNGAAGAGTAN
NNGANNGTGAAANGCACNGGGAGNTNACNCGAGCCGCCGNANNANGNGNTNTAACTTGTANGTTNNTTAGNAGNGCGNGN
GNTGNNCATNNGCGCNNGACAGGATTCCCGCNGNGGNGAG
Genus: Bacteria
Named: uncultured bacteria/ environmental sample
The 16 rRNA gene is a diverse gene that is specific to each species. For this test, a PCR for the 16S gene amplification was ran for the tetracycline positive plate with a dilution of -5, first sequence, and the standard broth plate with a dilution of -7, sequence 2. The first sequence did not show any result. This may have been because the sample was mixed with another groups sample in turn mixing up the genes in such a way that nothing could be read. The second sequence however further supported that the culture for this plate was in fact bacteria. However, the top sequence was simply identified as uncultured with no further information.
Work Cited
1. Kohanski, M., Dwyer, D., Collins, J. 2010. How Antibiotics Kill Bacteria. Nature Reviews. 8: 423-425
2. Lahr, D. J. G., Parfrey, L. W., Mitchell, E. A. D., Katz, L. A., & Lara, E. (2011). The chastity of amoebae: re-evaluating evidence for sex in amoeboid organisms. Proceedings of the Royal Society B: Biological Sciences, 278(1715), 2081–2090. http://doi.org/10.1098/rspb.2011.0289
Zebra Fish
https://docs.google.com/spreadsheets/d/1vYyd3K8GsJHscq2kn1tXZbKAOhavNaWt7qFG7IXjahE/edit#gid=0
The zebrafish were ultimately observed in both the control and experimental groups for fourteen days. Each day a total was taken of how many fish had died and the remaining were fed 15 microliters of shrimp using a P15. On days 4, 7, and 12 more detailed observations on development were taken of each fish type.
Day 1- Setting up the Fish
Purpose: Set up embryos in control and experimental groups so as to be able to observe them over the course of two weeks
Materials and Methods
Approximately forty-eight to sixty plus fish were retrieved and placed in a large petri dish for examination under a dissection
microscope. Forty-eight fish around the same embryonic stage were then found and placed into two separate petridishes with individual wells, one well for each fish. With the use of a transfer pipette with the tip cut off, each fish, while still in an early embryonic phase, was added to an individual well filled with 20mL of treated Deerpark water. The water was previously treated with methylene blue, an antifungal (lab). The embryonic stage of the fish was then noted. One dish was then placed under a box so as to be in constant darkness and the other was left on a lab bench and left to sit for three days.
Data and Observations
All fish were found to be in the 90% ploidy stage
Conclusion
All embryos appeared healthy but no other observations were made because it was only day one
Day 4- Measurement 1 of 4
Purpose- Retrieve all Beginning/ Initial Measurements Possible
Materials and Methods
On the day four, detailed observations were taken of one larvae from each group, the experimental and the control. First, the amount of hatched and non-hatched larvae were accounted for under a dissection microscope and all egg cases were removed from each well using a transfer pipette. Using two different transfer pipettes, one larvae from each group was then placed on a depression slide so as to be able to take further observation of each larvae in each group. Using the 4X objective, the size of each larvae was taken using the oncrometer. Their eye movement,
heart rate, pectoral fin development, yolk-sac size, development of the swim bladder and development of a mouth were also observed and noted. Their overall movement and speed under the microscope was also observed and judged using a 4 point scale with 0 being
no movement and 4 being constant, quick movement. Each fish was then put back in its respective well and 10mLs of treated Deerwater was removed and refreshed with 10 more using a transfer pipette. These observations will also be taken on day seven and day twelve.
Data and observations- see the google doc link at the top of this notebook
The control fish were larger than the experimental
More experimental embryos had died
Both the experimental and control group had minimal eye movement as well as overall movement
The experimental fish appeared to have a developed pectoral fin development while the control fish were still in an early development
Conclusion
The fish do not appear to be handling being in constant darkness. However in general, both groups of fish seem to be developing despite the conditions.
Material and Method set up for day 7 and day 12 will be the same as day 4
Day 7- 2nd of 4 Measurements to be taken of a Sample Fish from Each Group
Purpose- Retrieve 2nd of 4 Measurements to be taken of a Sample Fish from Each Group
Materials and Methods
See day 4 for initial measurements needed
On day seven, along with normal observations, three larvae were removed from each group and fixed in paraformaldehyde. To do so, the larvae were first added to 0.02% of tricaine to put them to sleep. Once asleep, a 4% solution of paraformaldehyde was added to the vial containing the larvae and tricaine solution to fix the fish. Both sets of fixed fish were then left to sit until day fourteen.
Data and Observations- see google doc at the top of the notebook
The experimental fish seem to be a lot quicker and more active than the control
The control fish are still larger than the experimental
Both group of fish have developed a mouth
Conclusion and Future Direction
While there has been death in both groups, it, death, does not appear to be happening in mass groups but rather one or two a day. While the experimental fish are smaller, they seem to move a lot quicker. However there is more eye movement happening in the control fish. Everything still seems to be on track with the hypothesis.
Day 12- 3rd of 4 Measurements to be taken of a Sample Fish from Each Group
Purpose- Retrieve 3rd of 4 Measurements to be taken of a Sample Fish from Each Group
Materials and Methods
See Day 4 for needed measurements
Data and Observations- see google doc link
Control fish are still larger but the experimental fish are still active
Experimental sample fish was found eating while under the microscope
Conclusions and Further Directions
All live fish do not appear to be changing much. Fish seem to be dying quicker but there doesn't seem to be a specific reason for either group's death. Development appears to still be somewhat on track with the experiment.
Day 14- Final Measurements and Observations of all Fish
Purpose- Take final observations on any still live fish and fixed fish
Materials and Methods
Since all fish were found to be dead after being observed under a dissection microscope, only an observation of an experimental, non-disnigrated fish was taken. A sample fixed fish for the experimental and control groups was also observed.
Data and Observations- see the google doc link
All fish were dead
Conclusion
At this point, all the fish had died. However after a quick skim of previous observations, it appears that the hypothesis held true for some parts of the experiment and not others.